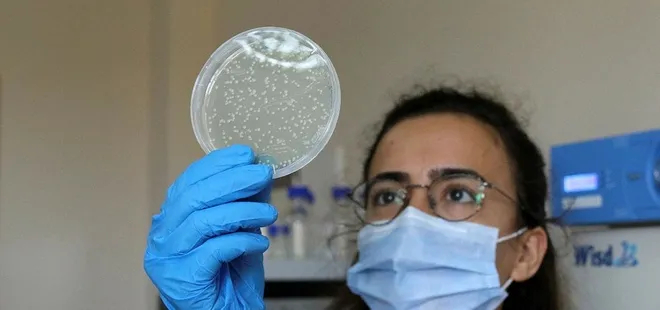
Akdeniz Üniversitesi’nde koronavirüse karşı aşı ve ilaç geliştirildi!

Akdeniz Üniversitesi'nde koronavirüse karşı aşı ve ilaç geliştirildi!
Son dakika haberine göre; Çin'de ortaya çıkan ve dünyayı etkisi altına alan koronavirüs ile ilgili araştırmalar devam ediyor. Akdeniz Üniversitesi’nde aşı çalışmalarını yürüten Ziraat Fakültesi Enzim ve Mikrobiyel Biyoteknoloji Bölümü Öğretim Üyesi Prof. Dr. Tarlan Mammedov ve ekibi tarafından koronavirüse karşı koruyucu sprey formunda da kullanılabilecek ilaç ve aşı geliştirildi.
Akdeniz Üniversitesi'nde aşı çalışmalarını yürüten Ziraat Fakültesi Enzim ve Mikrobiyel Biyoteknoloji Bölümü Öğretim Üyesi Prof. Dr. Tarlan Mammedov ve ekibi tarafından koronavirüse karşı koruyucu sprey formunda da kullanılabilecek ilaç ve aşı geliştirildi.

"Transient Bitki Ekspresyon Sistemi" ile bir tür tütün bitkisi olan Nicotiana Benthamiana'nın yapraklarında üretilen proteini temel alan ilaçla ilgili bilgi veren Prof. Dr. Mammedov, "Canlı virüsle yapılan testler olumlu sonuçlandı.
Tamamen bitkide üretilerek elde edilen proteinler, Covid-19 virüsünün hücreye girmesini engelliyor" ifadelerini kullandı.

ENZİM ÜRETİLDİ
Sprey olarak kullanılması durumunda virüsün hücreye girişini engellemek için büyük bir öneme sahip olan anjiyontensin dönüştürücü ACE2 enzimi üzerine çalıştıklarını anlatan Prof. Dr. Tarlan Mammedov, "Covid-19 virüsü bu enzimi bloke ediyor. Bu enzimin bedende azalması insanda önemli sağlık sorunlarına neden oluyor. Yoğun bakımda olan hastaların büyük bölümünde bu enzimin az miktarda bulunduğu gözlemlendi. Biz Transient Bitki Ekspresyon Sistemi ile bu enzimin yüksek oranda oluşturulmasını sağladık. Artık bu enzimi insanların hayatını kurtarmak için piyasaya sunmaya hazırız." şeklinde konuştu.

TEDAVİDE DE KULLANILABİLİR
Türkiye Sağlık Enstitüleri Başkanlığı Biyoteknoloji Enstitüsü Aşı Bilim Kurulu Üyesi olan Prof. Dr. Mammedov, bitkiden ürettikleri bu proteinlerin hem sprey hemdeenjeksiyon formlarında tedavide kullanılabileceğini belirterek, "Maddi kaynağın bulunması halinde tedavide kullanılacak olan ilaç4 ay içinde piyasaya sürülebilir" diye konuştu. Tarlan Mammedov,bitkide üretilen bu proteinlerinin koruyucu özelliğinin yanısıra, koronavirüs tedavisinde de uygulanabileceğini söyledi. Prof. Dr. Mammedov, "Enjeksiyon olarak üretimi yapılırsa, tedavi amaçlı olarak kullanılabilir. Ama bunun için faz 1 çalışmasının yapılması gerekiyor." ifadelerini kullandı.

KİTLER DE KULLANIMA HAZIR
Çalışmalarını aşı, ilaç ve kit olmak üzere 3 ayaklı sürdürdüklerini açıklayan Tarlan Mammedov, kit geliştirilmesinin de başarıyla sonuçlandığını duyurdu. Mammedov, "Vücudun antikor seviyesini ölçen kitler geliştirdik. Antikor seviyeleri yüksek olursa koronavirüse yakalanma riski daha azdır. Antikor seviyesi az olursa kişilerin yeniden koronavirüs hastalığına tutulma riski daha yüksektir. Biz de bu konuyla ilgili geliştirdiğimiz kitleri ticari olarak yapılan kitlerle karşılaştırdık ve analizlerde aynı sonuçları elde ettik. Bu kitler hastaların antikor seviyesini ölçmede kullanılabilir." dedi.

AŞIDA FAZ ÇALIŞMALARINA GELİNDİ
Prof. Dr. Mammedov, önemli bir aşama katettikleri aşı çalışmalarında da faz çalışmalarına geçmeye hazır olduklarını söyledi. Protein temelli aşıların diğer aşılara göre avantajlarına dikkat çeken Prof. Dr. Mammedov, "Protein temelli aşılar koronavirüsün çeşitli mutasyonlarına karşı etkili. Rekombinant protein temelli birkaç aşı adayı ürettik. Bu aşı adaylarında önemli testleri tamamladık. Hayvan testleri bu antijenlerin farelerde yüksek titreli antikor ürettiğini gösterdi. Bu da bitkide ürettikleri proteinlerin ümit verici bir aşı adayı olduğunu gösteriyor. Bu aşı adaylarının canlı virüslerle testlerini gerçekleştirdik. Canlı virüsün hücreye girmesini yüksek düzeyde engellediğini tespit ettik. Maddi destek sağlandığı takdirde Faz çalışmalarına geçmeye hazırız." diye konuştu.
 GÜNÜN MANŞETLERİ İÇİN TIKLAYIN
GÜNÜN MANŞETLERİ İÇİN TIKLAYIN





